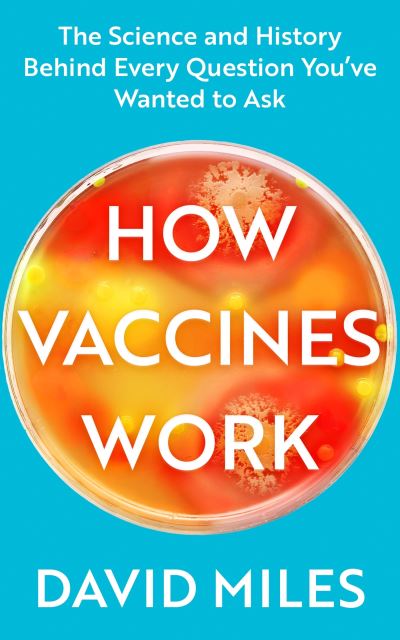

In Stock
Vaccinate
Paperback
€20.39
Collect 61 Reward Points
- Free Delivery from
- This Book Is Available Online Only
- Book Synopsis
- Vaccines are a debate, whether we want them to be or not. Now more than ever, it's easy to feel overwhelmed by the accusations and arguments that bloom across the news and internet. With a blend of science and history, HOW VACCINES WORK demystifies the strange and intricate world of vaccines: it explains what a vaccine is, how they are discovered and developed, and what happens when they meet our bodies. With over two decades of experience as an immunologist, David Miles gives expert insight into each vaccine routinely used in Britain, how they have kept us healthy, and why many people have come to worry about possible side effects. Through thrilling storytelling and in-depth exploration of the most common vaccination myths, HOW VACCINES WORK is the perfect guide to understanding all the vaccines we currently receive.
- About The Author
- David Miles has two decades of experience as a scientist and educator in the field of infectious disease immunology. He began his scientific career as a zoologist before moving to Gambia to study the infant immune response to vaccines against infectious diseases, and spent the ten years leading research projects there, in Malawi and in South Africa. David's research career was ended by a lymphoma, the treatment for which wiped out his immune system and left him more vulnerable to infection than a newborn baby. He moved into education as a tutor on the London School of Hygiene and Tropical Medicine's distance learning MSc in infectious diseases.
- Product Details
-
- ISBN
- 9780349428901
- Format
- Paperback
- Publisher
- Piatkus, (09 March 2023)
- Number of Pages
- 336
- Weight
- 580 grams
- Language
- English
- Dimensions
- 236 x 158 x 38 mm
- Categories: